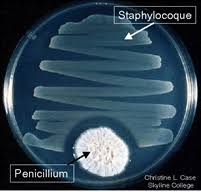
0/– Relação em que uma espécie inibe o crescimento ou sobrevivência de outra por meio de substâncias químicas, sem ser afetada

1/105
Looks like no tags are added yet.
Name | Mastery | Learn | Test | Matching | Spaced |
|---|
No study sessions yet.
O que é Ecologia?
🌱 Ramo da Biologia que estuda as relações dos seres vivos entre si e com o meio ambiente, incluindo componentes bióticos e abióticos.
O que são fatores bióticos?
🧬 Componentes vivos do ecossistema: seres vivos e suas interações (plantas, animais, microrganismos).
O que são fatores abióticos?
🌍 Componentes físicos e químicos do ambiente: luz, temperatura, água, solo, pH, salinidade, etc.
Definição biológica de espécie
🧬 Conjunto de indivíduos intercruzantes, capazes de gerar descendência fértil.
Definição ecológica de espécie
🌱 Conjunto de indivíduos que ocupam os mesmos nichos ecológicos em determinado ecossistema.
Definição genética de espécie
🧬 Conjunto de indivíduos que compartilham um grande pool gênico (conjunto de genes da população).
O que é população em Ecologia?
👥 Conjunto de organismos da mesma espécie que vivem em uma mesma área ao mesmo tempo
O que é comunidade (biocenose)?
🌿 Conjunto de populações de espécies diferentes que habitam uma mesma região e interagem entre si.
O que é ecossistema?
🌎 Conjunto formado pela comunidade (fatores bióticos) + meio físico (fatores abióticos) interagindo em uma área.
Por que ecossistema é um conceito relacional e não dimensional?
Porque tanto uma poça d’água quanto uma floresta podem ser ecossistemas, depende dos critérios de estudo, não do tamanho.
O que é bioma?
🗺️ Grande unidade biológica/geográfica com clima, solo, vegetação e fauna característicos (ex.: Amazônia, Cerrado).
O que é ecótono?
⚠️ Região de transição entre dois ecossistemas, com alta diversidade e geralmente baixa biomassa.

O que é hábitat?
📍 Local onde o organismo se encontra melhor adaptado, com melhores condições para sua sobrevivência.
O que é biosfera?
🌐 Conjunto de todos os ecossistemas da Terra, região onde existe vida (intersecção de litosfera, hidrosfera e atmosfera).
O que é nicho ecológico?
🧩 Conjunto de funções, hábitos e condições que a espécie desempenha e utiliza em um ecossistema (o “modo de vida” da espécie).
Por que o nicho ecológico é multidimensional?
Porque envolve várias dimensões ao mesmo tempo: tipo de alimento, horário de atividade, temperatura, umidade, local de reprodução, etc.
O que ocorre quando há grande sobreposição de nichos entre espécies diferentes?
❗ Ocorre forte competição, podendo levar à extinção local de uma das espécies (princípio da exclusão competitiva de Gause).
Diferença entre nicho fundamental e nicho realizado
🌈 Nicho fundamental = potencial total da espécie sem limitações ;nicho realizado = parte do nicho realmente ocupada, após competição e interações ecológicas.


Como se classificam as curvas de sobrevivência tipo I, II e III?
Tipo I: mortalidade maior nos indivíduos idosos; Tipo II: taxa de mortalidade constante; Tipo III: mortalidade alta nos indivíduos jovens (muitos morrem no início da vida)

O que são consumidores secundários, terciários, quaternários?
🦊 Secundários = comem herbívoros; terciários = comem consumidores secundários; quaternários = topo da cadeia, comem consumidores terciários.
Qual a diferença entre fluxo de energia e ciclagem de matéria?
⚡ Energia entra (luz solar), flui pelos níveis tróficos e é perdida como calor; já a matéria é reciclada dentro do ecossistema pelos decompositores.







O que diferencia relações harmônicas e desarmônicas?
✅ Harmônicas: trazem benefício sem prejuízo para as populações envolvidas ❌ Desarmônicas: pelo menos uma das espécies é prejudicada.




O que são endoparasitas?
🧬 Parasitas que vivem internamente no corpo do hospedeiro. Ex.: bactérias, protozoários, vermes intestinais.

Dê dois exemplos de amensalismo
🌲 Arbustos aromáticos que liberam toxinas no solo inibindo plantas herbáceas Arbustos aromáticos que liberam toxinas no solo inibindo plantas herbáceas; 🍄 fungo Penicillium produzindo penicilina que inibe bactérias




O que é protocooperação?




